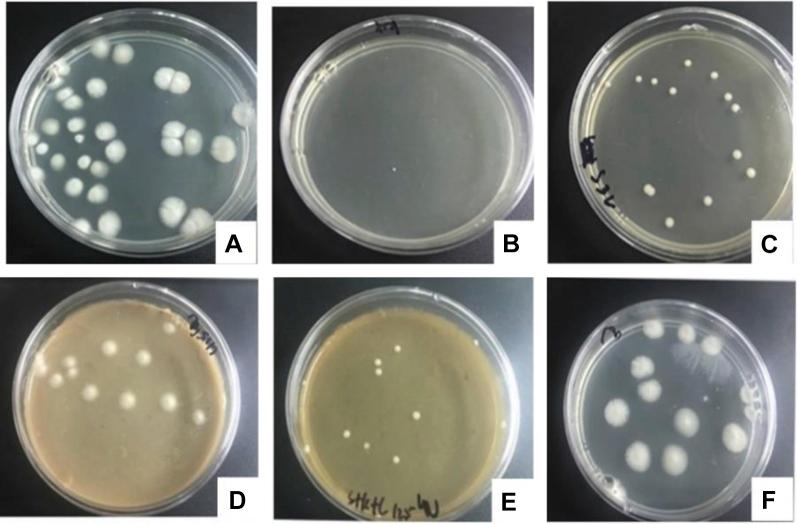
https://cdn.ncbi.nlm.nih.gov/pmc/blobs/88a5/7598122/c2c489958d0d/gr4.jpg

中药对禽类 Trichosporon 的抑菌作用研究。
Study on the bacteriostatic action of Chinese herbal medicine on avian Trichosporon.
机构信息
The College of Veterinary Medicine, Agricultural University of Hebei, Baoding 071001, China.
The College of Veterinary Medicine, Agricultural University of Hebei, Baoding 071001, China.
出版信息
Poult Sci. 2020 Sep;99(9):4530-4538. doi: 10.1016/j.psj.2020.06.011. Epub 2020 Jun 24.
In this study, a strain of Trichosporon was isolated from white pseudomembranes and ulcers formed on mucous membranes of pigeon bursas and was identified through gene sequencing. Bacteriostatic actions of Acorus gramineus, Sophora flavescens, Polygonum hydropiper, and Chinese herbal mixture on this species were explored in vitro, and the minimum inhibitory concentration of herbal medicines against Trichosporon was determined through microdilution method. Therapeutic effects of herbal medicines on chickens infected by Trichosporon were studied, whose results showed that minimum inhibitory concentration of A. gramineus was 32 μg/μL, that of S. flavescens was 2 μg/μL, that of P. hydropiper was 120 μg/μL, and that of Chinese herbal mixture was 36 μg/μL. Antibacterial effects of S. flavescens were the best. In accordance with animal experiments, therapeutic effects of Chinese herbal medicines on infected chickens were better than those of fluconazole. The mortality rate of the Chinese herbal medicine treatment group was 33.33%, that of the fluconazole treatment group was 46.67%, and that of the Chinese medicine protection group was 23.33%. The longer the time of Chinese medicine treatments was, the better the treatment effects would be. Glutamic oxaloacetylase values of the serum and liver in the Chinese herbal medicine treatment group were both significantly lower than those of the nontreatment group. From the results, it can be seen that A. gramineus, S. flavescens, P. hydropiper, and Chinese herbal mixture have certain inhibitory effects on Trichosporon spp. Chinese herbal medicine protections in advance could reduce Trichosporon infections.
在这项研究中,从鸽子的法氏囊的白色假膜和溃疡中分离出一株 Trichosporon,并通过基因测序进行鉴定。本研究还探索了菖蒲、苦参、水飞蓟和中草药混合物对该物种的体外抑菌作用,并通过微量稀释法测定了中草药对 Trichosporon 的最小抑菌浓度。研究了中草药对感染 Trichosporon 的鸡的治疗效果,结果表明菖蒲的最小抑菌浓度为 32μg/μL,苦参为 2μg/μL,水飞蓟为 120μg/μL,中草药混合物为 36μg/μL。苦参的抑菌效果最好。根据动物实验,中草药对感染鸡的治疗效果优于氟康唑。中草药治疗组的死亡率为 33.33%,氟康唑治疗组的死亡率为 46.67%,中药保护组的死亡率为 23.33%。中草药治疗时间越长,治疗效果越好。中草药治疗组血清和肝脏中的谷氨酸草酰乙酸值均明显低于未治疗组。结果表明,菖蒲、苦参、水飞蓟和中草药混合物对 Trichosporon 有一定的抑制作用。提前进行中药保护可以减少 Trichosporon 的感染。